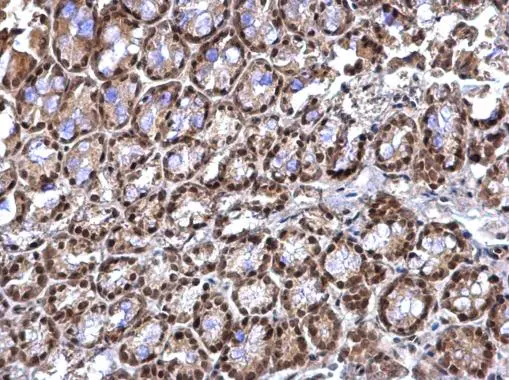
RED antibody detects RED protein at nucleus on mouse colon by immunohistochemical analysis. Sample: Paraffin-embedded mouse colon. RED antibody (GTX123169) dilution: 1:500. 
 Antigen Retrieval: Trilogy? (EDTA based, pH 8.0) buffer, 15min

Sample (30 ug of whole cell lysate) A: THP-1 B: HL-60 7.5% SDS PAGE GTX108398 diluted at 1:1000
RED antibody [N1], N-term
GTX108398
ApplicationsImmunoFluorescence, Western Blot, ImmunoCytoChemistry, ImmunoHistoChemistry, ImmunoHistoChemistry Paraffin
Product group Antibodies
ReactivityHuman
TargetIK
Overview
- SupplierGeneTex
- Product NameRED antibody [N1], N-term
- Delivery Days Customer9
- Application Supplier NoteWB: 1:500-1:3000. ICC/IF: 1:100-1:1000. IHC-P: 1:100-1:1000. *Optimal dilutions/concentrations should be determined by the researcher.Not tested in other applications.
- ApplicationsImmunoFluorescence, Western Blot, ImmunoCytoChemistry, ImmunoHistoChemistry, ImmunoHistoChemistry Paraffin
- CertificationResearch Use Only
- ClonalityPolyclonal
- Concentration1 mg/ml
- ConjugateUnconjugated
- Gene ID3550
- Target nameIK
- Target descriptionIK cytokine
- Target synonymsCSA2, RED, RER, protein Red, IK cytokine, down-regulator of HLA II, IK factor, RD element, chondrosarcoma-associated protein 2, cytokine IK, prer protein
- HostRabbit
- IsotypeIgG
- Protein IDQ13123
- Protein NameProtein Red
- Scientific DescriptionThe protein encoded by this gene was identified by its RED repeat, a stretch of repeated arginine, glutamic acid and aspartic acid residues. The protein localizes to discrete dots within the nucleus, excluding the nucleolus. Its function is unknown. This gene maps to chromosome 5; however, a pseudogene may exist on chromosome 2. [provided by RefSeq]
- ReactivityHuman
- Storage Instruction-20°C or -80°C,2°C to 8°C
- UNSPSC12352203

![RED antibody [N1], N-term detects RED protein at cytosol and nucleus on human colon carcinoma by immunohistochemical analysis. Sample: RED antibody [N1], N-term (GTX108398) dilution: 1:250.
Antigen Retrieval: Trilogy? (EDTA based, pH 8.0) buffer, 15min RED antibody [N1], N-term detects RED protein at cytosol and nucleus on human colon carcinoma by immunohistochemical analysis. Sample: RED antibody [N1], N-term (GTX108398) dilution: 1:250.
Antigen Retrieval: Trilogy? (EDTA based, pH 8.0) buffer, 15min](https://www.genetex.com/upload/website/prouct_img/normal/GTX108398/GTX108398_39953_IHC_w_23060120_850.webp)